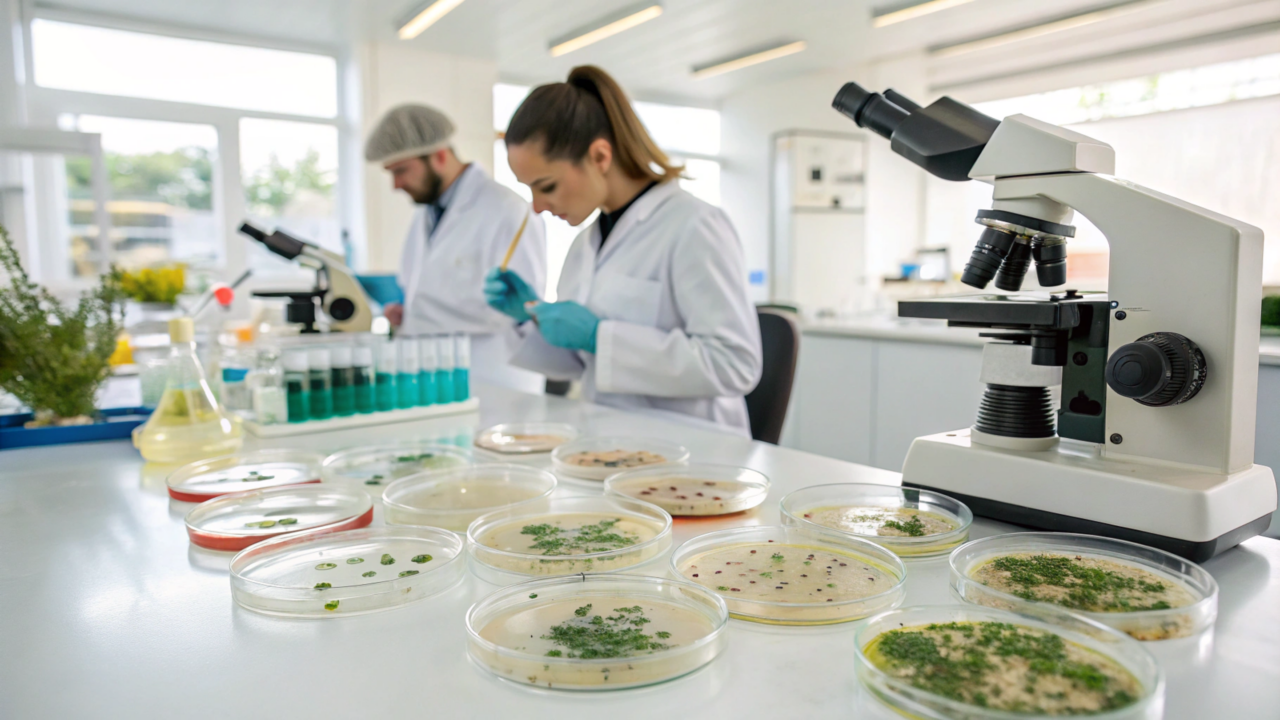
Nem planta, nem fungo, a ciência descobriu um novo reino dos seres vivos

Nem planta, nem fungo, a ciência descobriu um novo reino dos seres vivos
Prototaxites, gigante de 9 metros do Devoniano, desafia cientistas e pode representar um ramo perdido da evolução

Durante muito tempo, quem estuda a história da vida na Terra esbarrou em um mistério gigante, literalmente. Em meio a fósseis de pequenos musgos e artrópodes antigos, surgia uma estrutura cilíndrica de até 9 metros de altura, chamada Prototaxites, que não parecia se encaixar em nenhum reino conhecido e hoje é um dos melhores exemplos de como a ciência ainda está descobrindo novos caminhos da evolução.
Como era o mundo devoniano em que viveu o Prototaxites
No período Devoniano, há mais de 400 milhões de anos, a superfície terrestre era muito diferente da atual. Não existiam florestas densas, árvores altas ou grandes vertebrados em terra firme, e a paisagem era dominada por plantas baixas, musgos e pequenos líquens.
Artrópodes como miríápodes primitivos e aracnídeos ancestrais começavam a se aventurar fora da água. Em meio a esse cenário simples, o Prototaxites surgia como um cilindro ereto de até 9 metros, um verdadeiro “arranha-céu” biológico que foi um dos maiores organismos terrestres do planeta por cerca de 50 milhões de anos.
O que os cientistas pensavam sobre a origem do Prototaxites
Os primeiros estudos consideraram o Prototaxites um fungo gigante, semelhante a um cogumelo em formato de tronco. Essa ideia se baseava em suas células alongadas e entrelaçadas, parecidas com hifas de fungos, e no formato ereto, que lembraria uma estrutura reprodutiva.
Análises de morfologia e composição, porém, mostraram que ele não se encaixava bem nem como planta nem como fungo conhecidos. Isso levou alguns pesquisadores a propor que o Prototaxites poderia representar um novo ramo da árvore da vida, misturando características hoje separadas entre plantas e fungos.
Se você gosta de descobertas científicas e novidades do mundo natural, este vídeo do canal Macaco Despido, com 90,9 mil inscritos, foi escolhido para você. Nele, você conhece o recém-descoberto novo reino de seres vivos e entende a importância dessa descoberta para a biologia.
Como a análise de carbono ajudou a entender a alimentação do Prototaxites
Para investigar a nutrição desse organismo enigmático, cientistas estudaram a razão entre isótopos de carbono-12 e carbono-13 em seus fósseis. Plantas fotossintetizantes apresentam padrões relativamente estáveis, enquanto animais e fungos, que consomem outros organismos, exibem assinaturas isotópicas diferentes.
Os fósseis de Prototaxites mostraram proporções de isótopos mais parecidas com as de organismos heterotróficos, indicando que ele não produzia seu próprio alimento como uma planta. Ao mesmo tempo, sua estrutura não coincidia com a de animais, estreitando as possibilidades e reforçando seu caráter singular.
Quais hipóteses explicam o crescimento e o modo de vida do Prototaxites
A partir das evidências de carbono e dos fósseis disponíveis, surgiram diversas hipóteses para explicar como o Prototaxites crescia tanto em um ambiente com pouca biomassa terrestre. Pesquisadores consideraram desde modos de vida decompositores até associações complexas entre diferentes organismos.

O que estudos recentes revelam e por que o Prototaxites pode representar um novo reino
Em 2025, um estudo de um fóssil excepcionalmente bem preservado de Prototaxites taiti identificou estruturas internas semelhantes a tubos de transporte de gases ou líquidos, lembrando ao mesmo tempo sistemas de condução em animais e canais como xilema e floema em plantas. Além disso, foi observada a ausência de quitina, afastando ainda mais esse organismo dos fungos e artrópodes atuais.
A combinação de traços vegetais e fúngicos, somada ao padrão isotópico de organismos heterotróficos, levou especialistas a considerar o Prototaxites como um possível ramo quase perdido da evolução. Esse gigante do Devoniano pode ter sido parte de uma linhagem intermediária que testou soluções biológicas próprias, dominou paisagens antigas e desapareceu sem deixar descendentes conhecidos, lembrando que a árvore da vida é muito mais ramificada e misteriosa do que se imaginava.



Os comentários não representam a opinião do site; a responsabilidade pelo conteúdo postado é do autor da mensagem.
Comentários (0)